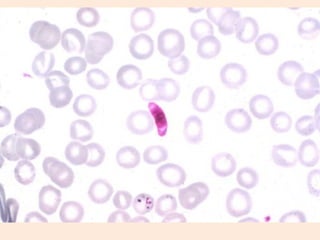

O documento descreve as características dos fungos, incluindo sua estrutura celular, formas de reprodução e diversidade. É detalhado o papel dos fungos na natureza e no dia-a-dia, como decompositores e na produção de alimentos e remédios. Também são apresentados três tipos de fungos - bolores, leveduras e cogumelos - e discutida a ocorrência de doenças fúngicas.